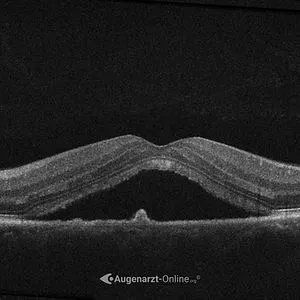
Chorioretinopathia Centralis Serosa (CRCS)

Netzhaut Spezialist in Wien | Dr. Seiller-Tarbuk
Chorioretinopathia Centralis Serosa
Die zentrale seröse Retinopathie entwickelt sich häufig plötzlich. Die Erkrankung betrifft vor allem Erwachsene mittleren Alters und Männer häufiger als Frauen. Typische Beschwerden sind verschwommenes oder verzerrtes zentrales Sehen, teils auch ein verkleinert wirkendes Bild oder Probleme beim Lesen.
Mit moderner Netzhautdiagnostik lässt sich die Verdachtsdiagnose bestätigen und evaluieren, wann eine Therapie sinnvoll ist.
Inhalt
Chorioretinopathia Centralis Serosa - Definition
Was ist Chorioretinopathia Centralis Serosa (CRCS)?


CRCS – einfach erklärt
Die zentrale seröse Chorioretinopathie ist eine Erkrankung der Makula, also jenes Bereichs der Netzhaut, der für scharfes Sehen verantwortlich ist. Dabei sammelt sich Flüssigkeit unter der Netzhaut an.
Ursache ist meist eine Störung im Zusammenspiel von retinalem Pigmentepithel und Aderhaut. Die Folge ist eine kleine Abhebung der Netzhaut im Zentrum, wodurch das Sehen verschwommen oder verzerrt wirkt.
Ist Chorioretinopathia Centralis Serosa heilbar?
Oft ja, aber nicht immer vollständig. Bei vielen Patienten bildet sich die Flüssigkeit unter der Netzhaut innerhalb von Wochen bis wenigen Monaten von selbst zurück. Das Sehen kann sich dann wieder deutlich erholen. Hält die Erkrankung jedoch länger an oder tritt sie wiederholt auf, sind bleibende Veränderungen an der Makula möglich.
Dann ist eine gezielte Behandlung wichtig. Bei chronischer CSC ist die PDT heute die am besten belegte Therapie.

CRCS – einfach erklärt
Die zentrale seröse Chorioretinopathie ist eine Erkrankung der Makula, also jenes Bereichs der Netzhaut, der für scharfes Sehen verantwortlich ist. Dabei sammelt sich Flüssigkeit unter der Netzhaut an.
Ursache ist meist eine Störung im Zusammenspiel von retinalem Pigmentepithel und Aderhaut. Die Folge ist eine kleine Abhebung der Netzhaut im Zentrum, wodurch das Sehen verschwommen oder verzerrt wirkt.
Ist Chorioretinopathia Centralis Serosa heilbar?
Oft ja, aber nicht immer vollständig. Bei vielen Patienten bildet sich die Flüssigkeit unter der Netzhaut innerhalb von Wochen bis wenigen Monaten von selbst zurück. Das Sehen kann sich dann wieder deutlich erholen. Hält die Erkrankung jedoch länger an oder tritt sie wiederholt auf, sind bleibende Veränderungen an der Makula möglich.
Dann ist eine gezielte Behandlung wichtig. Bei chronischer CSC ist die PDT heute die am besten belegte Therapie.
Chorioretinopathia Centralis Serosa - Risikofaktoren & Symptome
Wie erkennt man Chorioretinopathia Centralis Serosa?
Chorioretinopathia Centralis Serosa
Symptome
Eine Chorioretinopathia Centralis Serosa macht sich oft durch eine plötzliche Veränderung des zentralen Sehens bemerkbar.
Typisch sind verschwommenes Sehen auf einem Auge, verzerrte Linien, ein grauer oder dunkler Fleck in der Mitte, schlechteres Kontrastsehen oder der Eindruck, dass Gegenstände kleiner wirken als sonst.
Schmerzen verursacht die Erkrankung meist nicht.
Chorioretinopathia Centralis Serosa
Symptome
Eine Chorioretinopathia Centralis Serosa macht sich oft durch eine plötzliche Veränderung des zentralen Sehens bemerkbar.
Typisch sind verschwommenes Sehen auf einem Auge, verzerrte Linien, ein grauer oder dunkler Fleck in der Mitte, schlechteres Kontrastsehen oder der Eindruck, dass Gegenstände kleiner wirken als sonst.
Schmerzen verursacht die Erkrankung meist nicht.
Chorioretinopathia Centralis Serosa
Risikofaktoren
Besonders häufig tritt eine zentrale seröse Retinopathie bei Männern im mittleren Erwachsenenalter auf. Als wichtige Auslöser gelten vor allem eine Kortisontherapie und anhaltender psychischer oder körperlicher Stress.
Zusätzliche Faktoren wie Bluthochdruck oder Schlafapnoe können das Risiko weiter erhöhen. Da die Erkrankung wiederkehren oder länger bestehen bleiben kann, sind eine frühe Diagnose und regelmäßige Verlaufskontrollen wichtig, um das Risiko für bleibende Veränderungen an der Makula zu reduzieren.
Empfehlung
Bei bekannter CRCS werden Kontrolluntersuchungen empfohlen:
- ✓ Bei Erstdiagnose
- ✓ Alle 3 – 6 Monate
- ✓ Bei akuter Sehverschlechterung
Trifft eines dieser Kriterien auf Sie zu?
Jetzt Vorsorgetermin vereinbarenSymptome
- ✦ Plötzliche Sehverschlechterung
- ✦ Verzerrtes Sehen
- ✦ Dunkler Fleck im Sehzentrum
- ✦ Schwierigkeiten beim Lesen
- ✦ Gegenstände wirken kleiner als sonst
- ✦ Schwächere Kontraste und Farben
- ✦ Keine Schmerzen
Risikofaktoren
- 🚩 Kortisonhaltige Medikamente
- 🚩 Stress oder starke Belastung
- 🚩 Männliches Geschlecht
- 🚩 Häufig zwischen 30 und 50 Jahren
- 🚩 Bluthochdruck
- 🚩 Schlafapnoe oder Schlafstörungen
Chorioretinopathia Centralis Serosa - Diagnostik
Untersuchungen bei Chorioretinopathia Centralis Serosa
Anamnese
Arztgespräch

Am Beginn der Abklärung einer Chorioretinopathia Centralis Serosa steht ein ausführliches Gespräch. Dabei werden typische Risikofaktoren wie Stress, Kortisonanwendung, Begleiterkrankungen und aktuelle Veränderungen des Sehens genau besprochen.
Diese Angaben helfen, die Wahrscheinlichkeit einer CRCS besser einzuschätzen und die anschließende Diagnostik der Netzhaut gezielt auszurichten.

Chorioretinopathia Centralis Serosa - Therapie
Wie wird Chorioretinopathia Centralis Serosa behandelt?
Lebensstil
Bei einer frischen, akuten Chorioretinopathia Centralis Serosa ist nicht immer sofort eine Behandlung nötig. In vielen Fällen bildet sich die Flüssigkeit unter der Netzhaut innerhalb von Wochen bis wenigen Monaten von selbst zurück. Deshalb wird zunächst oft eine engmaschige Kontrolle mit OCT empfohlen. Gleichzeitig sollten mögliche Auslöser (Kortison, Stress, ...) gemieden werden.
PDT
Bei länger anhaltenden oder wiederkehrenden Verläufen ist die photodynamische Therapie, kurz PDT, derzeit die am besten belegte Behandlung. Ziel ist es, die undichte Stelle in der Aderhaut gezielt zu behandeln und die Flüssigkeit unter der Netzhaut zu reduzieren. In ausgewählten Fällen kann auch eine fokale Laserbehandlung sinnvoll sein, vor allem wenn die Leckage nicht direkt im Zentrum liegt.
Off-Label
Einige Medikamente wurden in der Vergangenheit auch Off-Label zur Behandlung der CSC eingesetzt (z.B. Eplerenon). Off-Label-Therapien gehören daher nicht zur Standardbehandlung und werden, wenn überhaupt, nur nach sorgfältiger individueller Abwägung besprochen. Bei chronischer CSC ist die PDT heute in der Regel die besser belegte Behandlungsoption.

Nehmen Sie plötzliche Veränderungen ernst!
Veränderungen im Sehzentrum sollten nicht einfach abgewartet werden. Mit moderner Diagnostik lässt sich rasch klären, ob eine CRCS oder eine andere Ursache für die Sehverschlechterung vorliegt.
Jetzt Termin vereinbarenChorioretinopathia Centralis Serosa - Leistungen
Angebot in meiner Ordination
Diagnose
Chorioretinopathia Centralis Serosa in Wien
Bei Verdacht auf eine Chorioretinopathia Centralis Serosa ist eine rasche augenärztliche Abklärung wichtig, insbesondere um andere behandlungsbedürftige Ursachen auszuschließen, welche ebenfalls plötzlich auftreten und das zentrale Sehen betreffen.
In meiner Ordination in Wien stehen moderne Diagnoseverfahren zur Verfügung, mit denen sich Veränderungen der Makula und Flüssigkeit unter der Netzhaut zuverlässig erkennen lassen.


Verlaufskontrolle
Chorioretinopathia Centralis Serosa in Wien
Wurde bei Ihnen eine Chorioretinopathia Centralis Serosa festgestellt, sind regelmäßige augenärztliche Kontrollen wichtig, um die Entwicklung des Befunds im Blick zu behalten. Dabei werden Veränderungen der Makula mit OCT-Aufnahmen dokumentiert und die Sehschärfe überprüft. So lässt sich erkennen, ob sich die Flüssigkeit unter der Netzhaut zurückbildet oder ob die Erkrankung weiter besteht.
Vor allem bei chronischen oder wiederkehrenden Verläufen ist eine engmaschige Kontrolle entscheidend. Ergänzend kann bei Bedarf eine Fluoreszenzangiografie durchgeführt werden, um die genaue Leckagestelle sichtbar zu machen. In speziellen Fällen kommen auch weitere bildgebende Verfahren wie OCT-Angiografie, Fundusautofluoreszenz oder Indocyaningrün-Angiografie zum Einsatz, um den Befund noch genauer einzuordnen und die weitere Behandlung gezielt zu planen.
Behandlung
Chorioretinopathia Centralis Serosa in Wien
Die Behandlung richtet sich nach dem Verlauf der Erkrankung. Bei einer akuten Chorioretinopathia Centralis Serosa reicht zunächst oft eine engmaschige Kontrolle, da sich die Flüssigkeit unter der Netzhaut häufig von selbst zurückbildet. Bleibt der Befund bestehen oder tritt die Erkrankung wiederholt auf, kann eine gezielte Therapie notwendig werden.
Als wichtigste Behandlung bei chronischer CSC gilt heute die PDT. In ausgewählten Fällen kann auch eine Laserbehandlung sinnvoll sein. Alle Behandlungen werden individuell auf Ihren Befund abgestimmt.

Diagnose
Chorioretinopathia Centralis Serosa in Wien
Bei Verdacht auf eine Chorioretinopathia Centralis Serosa ist eine rasche augenärztliche Abklärung wichtig, insbesondere um andere behandlungsbedürftige Ursachen auszuschließen, welche ebenfalls plötzlich auftreten und das zentrale Sehen betreffen.
In meiner Ordination in Wien stehen moderne Diagnoseverfahren zur Verfügung, mit denen sich Veränderungen der Makula und Flüssigkeit unter der Netzhaut zuverlässig erkennen lassen.

Verlaufskontrolle
Chorioretinopathia Centralis Serosa in Wien
Wurde bei Ihnen eine Chorioretinopathia Centralis Serosa festgestellt, sind regelmäßige augenärztliche Kontrollen wichtig, um die Entwicklung des Befunds im Blick zu behalten. Dabei werden Veränderungen der Makula mit OCT-Aufnahmen dokumentiert und die Sehschärfe überprüft. So lässt sich erkennen, ob sich die Flüssigkeit unter der Netzhaut zurückbildet oder ob die Erkrankung weiter besteht.
Vor allem bei chronischen oder wiederkehrenden Verläufen ist eine engmaschige Kontrolle entscheidend. Ergänzend kann bei Bedarf eine Fluoreszenzangiografie durchgeführt werden, um die genaue Leckagestelle sichtbar zu machen. In speziellen Fällen kommen auch weitere bildgebende Verfahren wie OCT-Angiografie, Fundusautofluoreszenz oder Indocyaningrün-Angiografie zum Einsatz, um den Befund noch genauer einzuordnen und die weitere Behandlung gezielt zu planen.

Behandlung
Chorioretinopathia Centralis Serosa in Wien
Die Behandlung richtet sich nach dem Verlauf der Erkrankung. Bei einer akuten Chorioretinopathia Centralis Serosa reicht zunächst oft eine engmaschige Kontrolle, da sich die Flüssigkeit unter der Netzhaut häufig von selbst zurückbildet. Bleibt der Befund bestehen oder tritt die Erkrankung wiederholt auf, kann eine gezielte Therapie notwendig werden.
Als wichtigste Behandlung bei chronischer CSC gilt heute die PDT. In ausgewählten Fällen kann auch eine Laserbehandlung sinnvoll sein. Alle Behandlungen werden individuell auf Ihren Befund abgestimmt.


Ordination
Weintraubengasse
✓ Individuelle Beratung
- Ausführliche Befundbesprechung
- Persönliche Einschätzung des Verlaufs
- Klare Empfehlung
✓ Modernste Ausstattung
- Spaltlampenuntersuchung
- OCT
- Fluoreszenzangiographie
✓ Fundierte Expertise
- Bester Österreicher (European Board Exam 2024)
- Stv. Leiter der Augenambulanz BBWien
Krankenhaus
Barmherzige Brüder Wien
✓ Weiterführende Netzhauttherapie
- Diagnostik und Therapie aus einer Hand
- Photodynamische Therapie (PDT)
- Laserkoagulation (in ausgewählten Fällen)
✓ Anbindung an die Netzhautambulanz
- Nahtlose Weiterbetreuung
- OCT-Angiographie
- Fluoreszenzangiographie
Chorioretinopathia Centralis Serosa - Infomaterial
CRCS - Zusätzliche Informationen
Häufige Fragen (FAQ) ›
Was ist eine Chorioretinopathia Centralis Serosa (CRCS)? +
Die Chorioretinopathia Centralis Serosa (CRCS, auch CSC genannt) ist eine Erkrankung der Makula, bei der sich Flüssigkeit unter der Netzhaut ansammelt. Ursache ist eine Störung im Zusammenspiel zwischen Pigmentepithel und Aderhaut. Sie tritt häufig plötzlich auf und betrifft vor allem Männer im mittleren Erwachsenenalter.
Welche Symptome deuten auf eine CRCS hin? +
Typische Symptome sind eine plötzliche Sehverschlechterung auf einem Auge, verzerrtes Sehen, ein grauer oder dunkler Fleck in der Bildmitte, reduziertes Kontrastsehen und der Eindruck, dass Gegenstände kleiner wirken als sonst. Schmerzen verursacht die CRCS meist nicht.
Wer ist besonders gefährdet? +
Besonders gefährdet sind Männer zwischen 30 und 50 Jahren. Als wichtige Auslöser gelten Kortisontherapie und anhaltender psychischer oder körperlicher Stress. Auch Bluthochdruck und Schlafapnoe können das Risiko erhöhen.
Ist eine CRCS heilbar? +
Oft ja, aber nicht immer vollständig. Bei vielen Patienten bildet sich die Flüssigkeit innerhalb von Wochen bis wenigen Monaten von selbst zurück, das Sehen erholt sich dann wieder deutlich. Hält die Erkrankung länger an oder tritt wiederholt auf, sind bleibende Veränderungen an der Makula möglich.
Wie wird eine CRCS diagnostiziert? +
Die Diagnose erfolgt durch Spaltlampenuntersuchung des Augenhintergrunds und vor allem durch hochauflösende OCT-Bildgebung, mit der die Flüssigkeit unter der Netzhaut sichtbar gemacht wird. Bei Bedarf ergänzt die Fluoreszenzangiographie die Diagnostik, um die genaue Leckagestelle zu lokalisieren.
Was ist die photodynamische Therapie (PDT)? +
Die photodynamische Therapie ist die derzeit am besten belegte Behandlung bei chronischer CRCS. Dabei wird ein lichtaktivierbarer Farbstoff in die Vene injiziert, der sich in der krankhaften Aderhautregion anreichert. Ein Laser mit spezieller Wellenlänge aktiviert den Farbstoff und behandelt gezielt die undichten Gefäße — ohne die darüberliegende Netzhaut zu schädigen.
Wann ist eine Behandlung notwendig? +
Bei einer akuten CRCS wird zunächst oft abgewartet, da sich die Flüssigkeit häufig innerhalb einiger Monate von selbst zurückbildet. Eine Behandlung (meist PDT) wird empfohlen, wenn der Befund länger als 3–6 Monate bestehen bleibt, wiederholt auftritt oder eine rasche Sehverschlechterung droht.
Was kann ich selbst tun? +
Wenn möglich sollten Kortison-haltige Medikamente (auch Salben, Nasensprays, Inhalatoren) gemeinsam mit dem behandelnden Arzt überprüft und reduziert werden. Stressreduktion, ausreichend Schlaf und Behandlung einer eventuellen Schlafapnoe sind ebenso wichtig. Regelmäßige augenärztliche Kontrollen zur Verlaufsdokumentation sind entscheidend.
Kann eine CRCS wiederkommen? +
Ja, eine CRCS kann wiederkehren, vor allem wenn Risikofaktoren wie Kortison oder Stress weiter bestehen. Auch eine chronische Verlaufsform ist möglich. Deshalb sind regelmäßige OCT-Kontrollen und die konsequente Kontrolle der Auslöser wichtig.
Führt eine CRCS zur Erblindung? +
Eine CRCS führt in aller Regel nicht zur Erblindung. Bei chronischen oder wiederkehrenden Verläufen kann es jedoch zu bleibenden Veränderungen an der Makula und einer dauerhaften Sehminderung kommen. Eine frühzeitige Diagnose und konsequente Verlaufskontrolle sind der beste Schutz.










